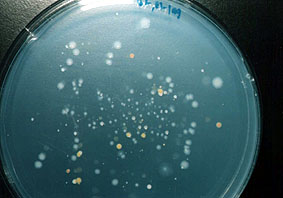
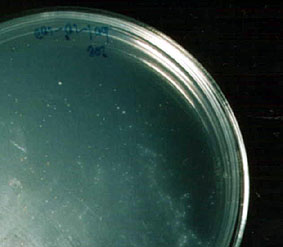

最初に:このページはサイアス1999年12月号に掲載された記事を手直ししたものです。
地下深くに広がるバクテリア・ワールド
日本の地下バクテリア研究の状況
 私たちが踏みしめる大地のはるか奥深く、地中深い岩石の中に生物がいる。
私たちが踏みしめる大地のはるか奥深く、地中深い岩石の中に生物がいる。
その可能性が科学的に示されたのは比較的古いが、本格的な調査は始まってまだ日が浅い。分かっているのは地下数百m以上の深さで生活する生物は、そのほとんどがバクテリアであること。また、彼らの分布はおそらく地下数kmにまでおよんでいること。そして私達が想像する以上に豊富で多様な生物圏が地下に存在するということである。
1999年6月、日本初の地下生物圏シンポジウムにおいて広島大学の村上由記は、岐阜県・東濃地域の深さ数百mの地下水における調査結果を発表した。彼女によるとこの地域の地下水には1ミリリットル(つまり1立方センチ)あたり10万~100万ものバクテリアがいることが確認できたという。この数字は驚くべきことに海洋表面の海水中におけるバクテリアの密度にほぼ匹敵するものだ。
海の表面の海水と深度数百mの地下水とではバクテリアを取り巻く条件が大きく異なる。例えば海水中には生物のさまざまな分解産物である有機物が溶け込み、太陽光線も酸素も豊富に含まれる。
一方、地下深くの岩石中にはそれほど有機物が多くないか、あるいは花崗岩のようにほとんど含まれていない。また地下水中では分子状の酸素はあったとしてもわずかであろうと思われる。では地下バクテリアはどのようにくらしているのだろうか。
太陽光線を用いて有機物を合成(光合成)し、分子状酸素で酸化することでエネルギーをつくり出す(呼吸)。私たちを含めて、多くの地上生物はこのような方法で生きているが、地下では光合成などまったく不可能だ。また、分子状酸素を用いた呼吸を行うこともあまり期待できない。とはいえ堆積岩の中なら私達になじみのある生活スタイルを送ることがある程度ならできる。例えば砂が堆積してできた砂岩はすきまが大きくて水をよく通すし、一緒に堆積した植物など生物の遺骸を含んでいる。一部の地下バクテリアたちはこのような岩石に含まれる有機物や地下水中のわずかな分子状酸素を使って生きているらしい。
一方、分子状酸素を用いずに必要なエネルギーを作って生きていけるバクテリアも知られている。こうした代謝を行うバクテリアは酸素が少ないか、あるいはまったく無い環境、例えば空気の通りが悪い泥や土の中にいるが、深部地下の探査によって非常に深い地下世界でも生きていることが分かってきた。いやむしろ彼らが地下バクテリアの主要な構成員であると考えられている。
一般にバクテリアは形が単純で変化に乏しいように思われているが、少なくとも代謝のバリエーションに関してはとても多様性が大きい。私たち酸素呼吸生物は食べた有機物を分子状の酸素で酸化してエネルギーをつくり出すが、何種類かのバクテリアは分子状酸素(O2)ではなく、化合物の形になっている酸素、つまり硫酸イオンや硝酸イオン、あるいは鉄イオンやマンガンイオンで有機物(あるいは無機物)を酸化してエネルギーをつくり出すことができる。その一方で彼らの多くは分子状酸素を好まない。村上が今回報告したいくつかのバクテリアもそういう種類だった。
村上が東濃地域で地下水を採取した孔は試錐孔(しすいこう)と呼ばれ、核燃料サイクル開発機構の東濃地科学センターが掘ったものだ。試錐孔は深部地下水の挙動を調べるために使われているもので、地下水を自然な状態で手に入れることができる。例えば試錐孔の1つ DH-3 は最深部が840mに達し、花崗岩の岩盤の中にある地下水を採取できる。
さて、花崗岩はマグマが冷えてできた火成岩の一種なので、生物由来の有機物など含んでいない。にもかかわらず、外国の報告では火成岩をつくる鉱物のすきまや、天然ガラスの裂け目からさえもバクテリアが見つかっている。そして同じように村上も DH-3 から採取した地下水にバクテリアがいることを確認した。
村上が DH-3 から見つけたバクテリアには鉄還元細菌と硫酸還元細菌が含まれていた。これらのバクテリアは、先に述べたような有機物(あるいは無機物)を、化合物の形になっている酸素で酸化することによりエネルギーを作っている種類だ。つまり鉄還元細菌は第3鉄イオンで、硫酸還元細菌は硫酸イオンを使ってエネルギーをつくり出す。おかげで彼らは分子状酸素にも、有機物にも乏しい地中深くの花崗岩の中で生活できるらしい。
さて、彼らが行っているこれらユニークな反応は私達の呼吸に対応するものだ。実際、”硫酸呼吸”という用語もある。もっともこうした”呼吸”によって生み出されるエネルギーは、私達の”分子状酸素を用いた呼吸”よりもはるかに少ない。このことは彼らの培養にかなり時間がかかることに端的に現れている。
一部の研究者は地下の環境が劣悪なために、地下に住むバクテリアは飢餓状態にあり成長が異常に遅く。場合によっては1回の分裂に100年かかるのではないかという意見もある。
もっとも村上は調査中に分裂の途中と思われるバクテリアを見つけている。この事実は地下バクテリアのすべてが極端に遅く成長するわけではないことを示しているようだ。ただし、村上が所属する研究室の長沼毅助教授が指摘するように、これが地上由来のバクテリアである可能性も捨てきれないわけで、今後の調査結果が待たれる。

試錐孔AN-6 から得られた分裂途中と思われるバクテリアの電子顕微鏡写真。中央の2つのラグビーボールがくっついたようなものがバクテリア。背景の網目状のものはバクテリアを漉しとるためのメッシュ。
(村上由記さんに許可をもらって掲載)
地下バクテリアの調査では、地下水や岩石のような地下のサンプルが地上のバクテリアに汚染される可能性が常にある。調査用の孔はドリルで掘られ、削られた岩石の屑はドリルを通じて送り込まれた掘削用泥水によって取り除かれる。しかし、このことは地下バクテリアの探査には少しばかり都合が悪い。掘削用泥水は地上から送り込むわけだから、泥水に混ざった地上のバクテリアが地下の岩石や地下水に入り込むことになる。つまり地下の世界が地上の生物で汚染されてしまうわけだ。こうした汚染の影響はどの程度のものになるのだろう。
村上が地下水を採取した2つの試錐孔 DH-3 と TH-6 は、いずれも泥水ではなく清水を使って掘ったもので、比較的汚染が少ないと考えられている。
さらに、東濃地科学センターの岩月輝希によると、最初、試錐孔の中の水には掘削に用いた水が混ざっているが、水をくみ出していくと水質は変化していき(つまり周囲の岩盤からしみ出してくる地下水が混ざることで水質が変化していく)、そして最終的に安定する。このように水質が安定すると掘削に用いた地上の水に由来するトリチウムももはや検出されなくなる。このことは掘削用の水が周囲からしみ出してきた地下水に完全に置き換えられたと考えてよい結果だ。
村上の調査に用いられたのはこのようにして水質が安定した水である。それでも地上生物による汚染の可能性は残る。そこで、最近掘削が終わって、水をくみ出している最中の試錐孔 DH-7 で定期的な調査が行われている。ここから検出されるバクテリアの変遷を見ていけば、地上バクテリアによる汚染とその影響がどの程度のものなのか、それが明らかになっていくだろう。
試錐孔DH-7 、深さ601m の花崗岩帯の地下水から得られたバクテリアのコロニー。コロニーの色や形から5種類あまりのバクテリアが確認できる。好気的な条件で培養したもの。
いずれにせよ、村上は、調査した DH-3 . TH-6 では深度によってバクテリアの形態がかなり異なっていることを見い出している。これらのバクテリアが掘削水による汚染であるのならば、試錐孔のどこでも同じ種類が見られるはずだ。このことはたとえ地上バクテリアによる汚染があったにしても、それが小規模であったことを示していると思われる。
さて、地下深い岩石の中にいるバクテリアたちはお互いに関わりをもたず、乏しい有機物をゆっくり食べているわけではない。彼らはそれなりの生態系を作っているらしい。先に村上は鉄還元細菌と硫酸還元細菌を見つけたと書いたが、彼女はさらに地下水の中に鉄酸化細菌がいるのを確認した。鉄”還元”細菌と鉄”酸化”細菌、名前はまぎらわしいが、両者の代謝はいわば正反対のものだ。
鉄還元細菌は有機物などを第3鉄イオンで酸化してエネルギーを作り、第2鉄イオンをいらないものとしてはきだしているが、(人間が二酸化炭素をはきだすのと同じ)
鉄酸化細菌の方は第2鉄イオンを酸化してエネルギーをつくり出し、いらないものとして第3鉄イオンをはきだしている。
以上のことから分かるように、この2種類のバクテリアがはきだしている代謝産物はお互いに利用できるものなのだ。そのため、長沼助教授は彼らが相手の作った鉄イオンをお互いに利用しあっている可能性を指摘する。
鉄酸化細菌のコロニー(白い小さな点々)。試錐孔DH-7 深度601mから得られた地下水から培養されたもの。
また、同じようなことは硫酸還元細菌のつくり出す硫化水素(卵の腐ったような臭いのする気体)に関しても同じかもしれないと、長沼助教授は言う。なぜなら硫化水素を酸化してエネルギーをつくり出す硫黄酸化細菌という種類のバクテリアがいるからだ。
以上のような”生態系”はお互いに利用しあっている生産物が化学物質だということになる。長沼助教授は冗談まじりに『食物連鎖反応』と呼んでいる。
さらに幾人かの外国の研究者たちは地上由来の物質にまったく頼らないバクテリアの生態系がありうることを示している。こうした生態系を支えるのは地上のような太陽光線ではなく、地球深部から上がってくるガスだ。
パシフィック・ノースウエスト研究所のスティーブンス・マッキンリーたちは、地球の深部で高温の岩石と水が反応することによって水素が作られていることを指摘する。水素はある種のバクテリアにとって直接エネルギーの源になる。例えば、メタン生成細菌と呼ばれるバクテリアは水素を二酸化炭素で”酸化”して生存に必要なエネルギーを作っている。奇妙に聞こえるだろうが、彼らは二酸化炭素で”呼吸”しているのだ。
こうしたバクテリアは地上から供給される有機物や分子状酸素を利用する必要はない。彼らは地下で完全に自立して生活していくことができるし、同時に彼らが排出した有機物は他の種類のバクテリアの貴重な栄養となるだろう。要するに彼らの作る生態系は、はるか地下深くから水素が供給される限り永久に維持される。
こうした予想ほど劇的ではないにせよ、村上は DH-3 の地下数百m以上から採取された地下水は強い還元状態であるため、通常は分子状酸素を代謝に用いているバクテリアでさえ、硝酸イオンを使った呼吸をしているのではないかと推測している。
また、彼女は鉄還元細菌や鉄酸化細菌、硫黄還元細菌の数が深度によってかなり変化することも発見した。これは地下の環境が決して一定でないことを反映したものだ。
例えば、地下の環境は深くなるにつれて鉱物と地下水が反応して還元的に、pH でいうと弱アルカリ性になっていく。村上は鉄に依存するバクテリアについて見ると、鉄がバクテリアにとって利用しやすい状態になる pH と酸化還元電位の深度でバクテリアの数が多くなることを見つけている。
地下の環境は、深度や鉱物の違いによる影響でかなり違っていることが分かっている。例えば東濃地科学センターの調査では、東濃地域の堆積岩と花崗岩の境、わずか数mの間で pH が大きく変わることが知られているし、過去の地震などでできた亀裂や破砕帯では地下水の移動が他の場所よりは大きい。このような環境の変化に応じて地下バクテリアの数や種類は変化する。私達が思っている以上に地殻深部の岩石の中はにぎやかな場所らしい。
さて、地下深部の岩石の中はまったくの無生物、つまりバクテリアさえもいない場所である、そんな”常識”がくつがえされたのは、米国エネルギー省がサウスカロライナ州の地殻を掘削した1987年が最初だ。それ以来、地下バクテリアの存在は科学的な興味のみならず、地殻の無菌状態を前提としていた計画や予想に影響を与えうるものとして関心をさそった。
例えば、地殻深部に長期間置かれる物体、核コンテナやその他の廃棄物などの容器は地上同様、バクテリアの活動を考慮しなくてはいけないかもしれない。また、逆に岩石中のバクテリアは放射性元素などの拡散を防ぐかもしれないし、人間が汚染してきた地下水を浄化してくれるかもしれない。あるいはこうしたことはいずれも起きないかもしれない。
このように可能性が取りざたされる一方で、研究に必要な設備を整えることは難しい。
例えば、地上のバクテリアの汚染を防ぐことは地下バクテリアの研究には必要不可欠な条件だが、これを実行するのは想像以上に困難だ。例えば岩石のコアは採取する際に掘削水がしみ込むので、当然、その部分は汚染されているとみなさなければならない。そのため、汚染をまぬがれている部分を削り出さなければならないのだが、その作業は無菌状態で行わなければ意味がない。さらに分子状酸素が少ないか、あるいは全く無い環境にすむバクテリアを取り出すのだから作業する場所は無酸素であることが望ましい。
岩石を削る作業に必要なスペースを無菌状態で、なおかつ無酸素の状態にするにはどうしたらよいのだろうか?。少し想像力を働かせると、それがいかにやっかいなことであるかが分かるだろう。
最近、長沼助教授のチームは東濃地科学センターと共同で地下バクテリアを研究するラボを開設した。このラボは以前ウラン鉱石の調査を行っていた東濃鉱山の地下128mに設置されたものだ。長沼助教授は『この分野の基本的な部分でさえ、日本の研究者がやれること、やるべきことは数多く残っている』と話している。
(文中敬称略):また、写真掲載の許可はすべて研究者である村上由記さんからいただいた。